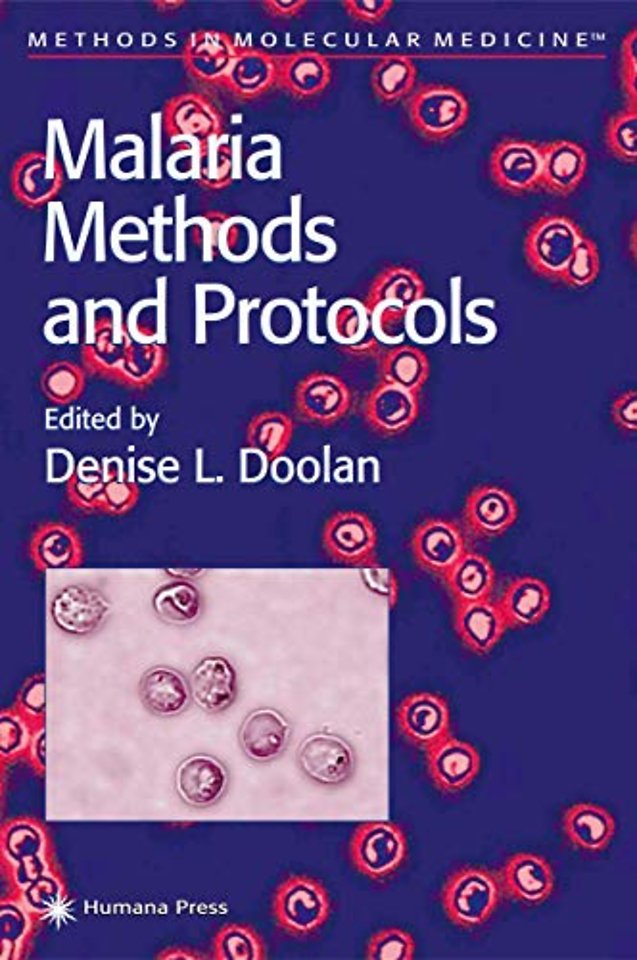
Malaria Methods and Protocols

Malaria Methods and Protocols
Samenvatting
The Plasmodium spp. parasite was identified as the causative agent of malaria in 1880, and the mosquito was identified as the vector in 1897. Despite subsequent efforts focused on the epidemiology, cell biology, immunology, molecular biology, and clinical manifestations of malaria and the Plasmodium parasite, there is still no licensed vaccine for the prevention of malaria. Physical barriers (bed nets, window screens) and chemical prevention methods (insecticides and mosquito repellents) intended to interfere with the transmission of the disease are not highly effective, and the profile of resistance of the parasite to chemoprophylactic and chemotherapeutic agents is increasing. The dawn of the new millennium has seen a resurgence of interest in the disease by government and philanthropic organizations, but we are still faced with compl- ities of the parasite, the host, and the vector, and the interactions among them. Malaria Methods and Protocols offers a comprehensive collection of protocols describing conventional and state-of-the-art techniques for the study of malaria, as well as associated theory and potential problems, written by experts in the field. The major themes reflected here include assessing the risk of infection and severity of disease, laboratory models, diagnosis and typing, molecular biology techniques, immunological techniques, cell biology techniques, and field applications.